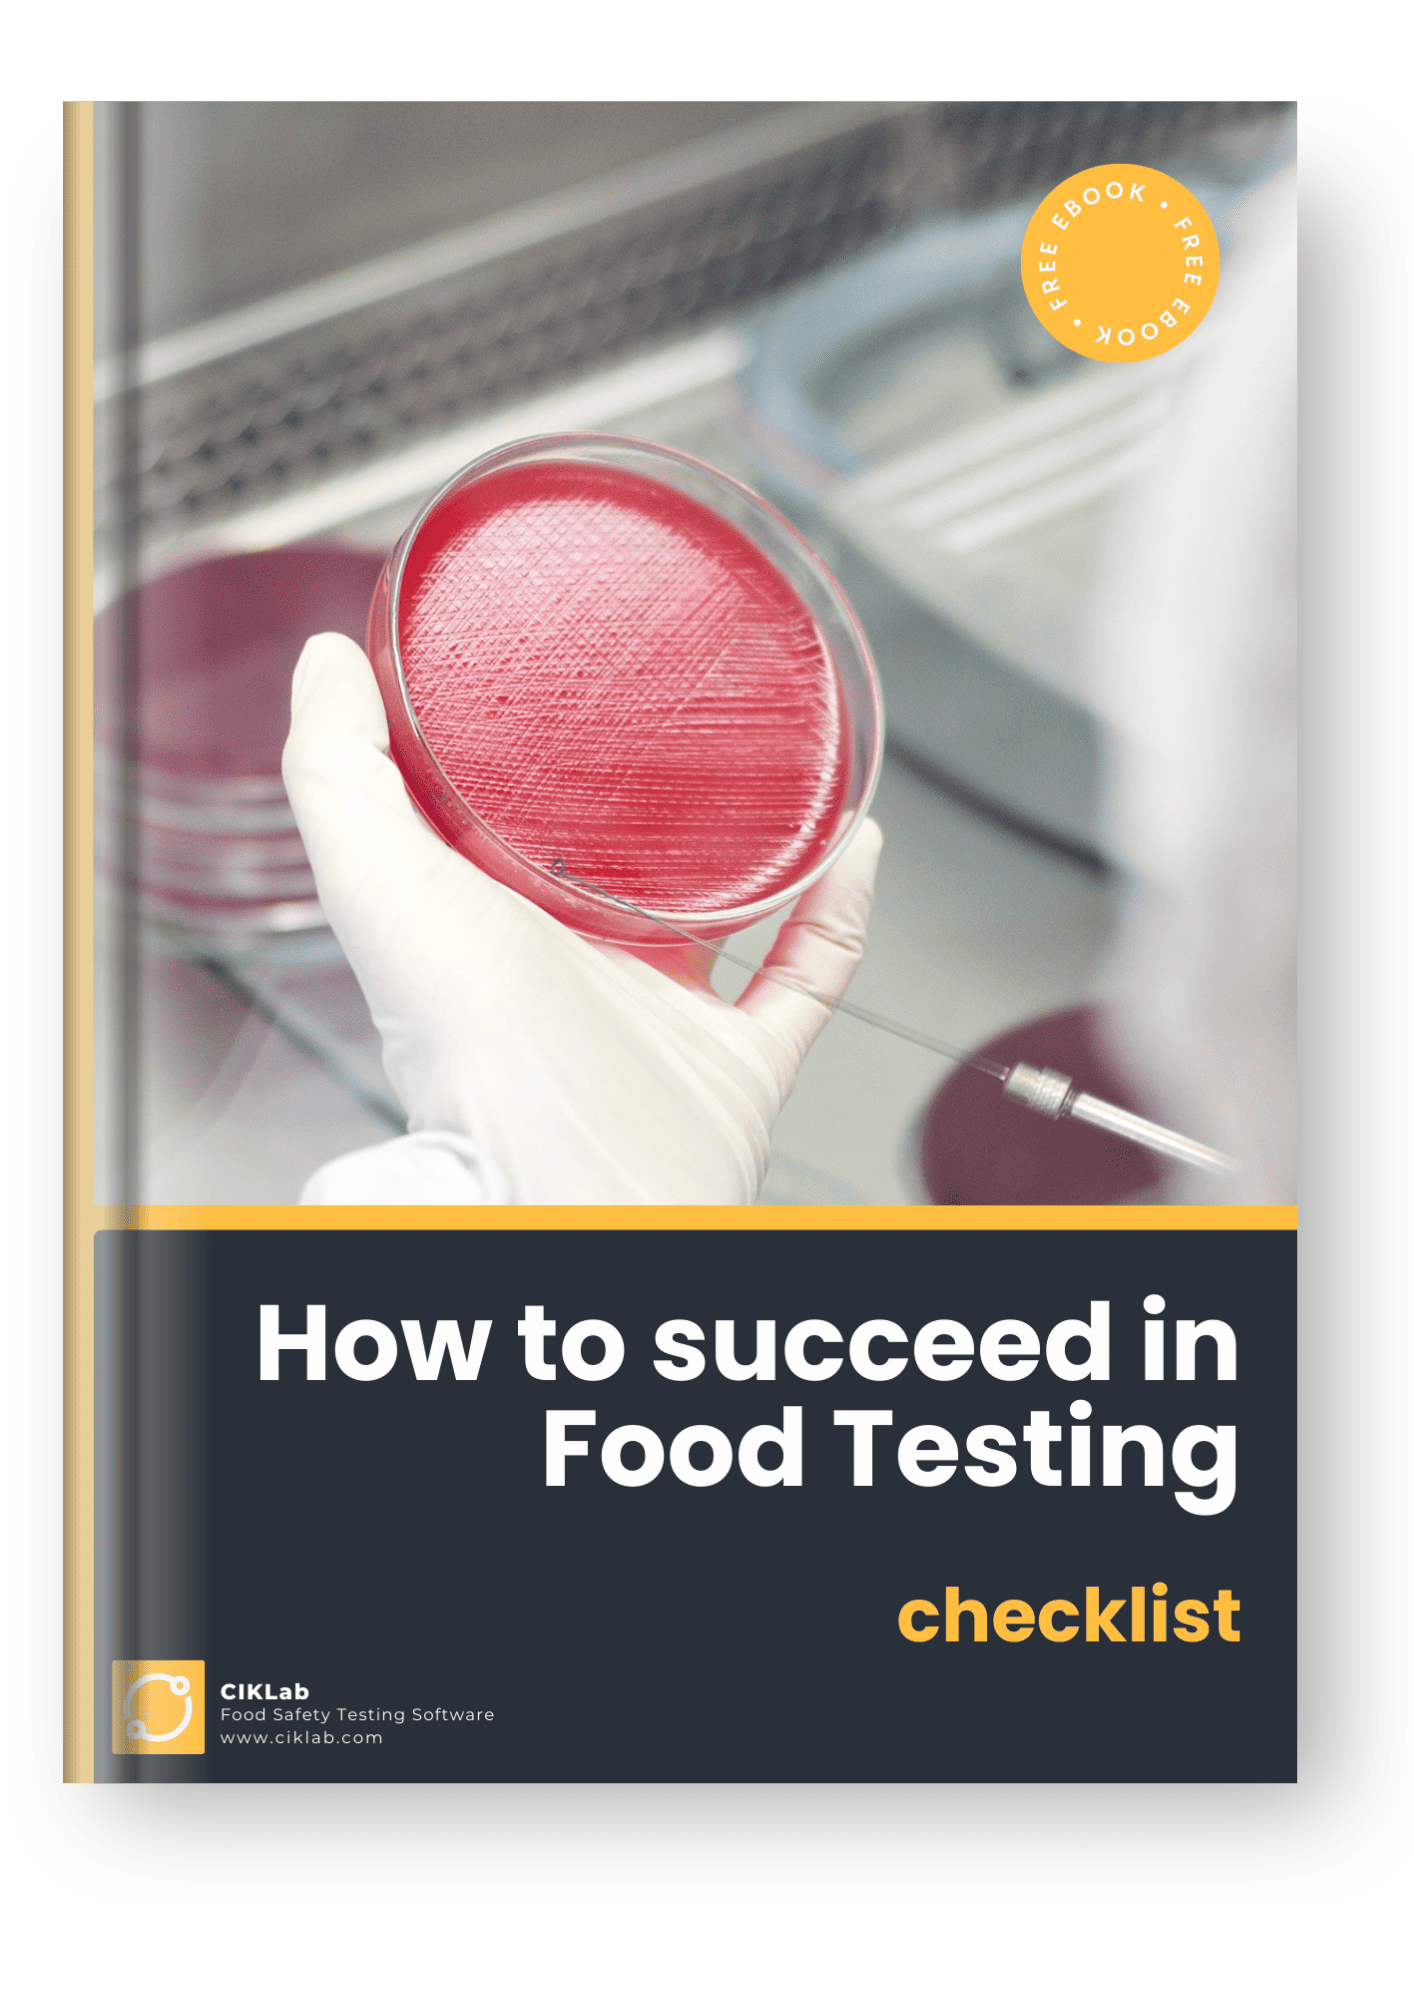
How to succeed in food testing-1

CHECK-LIST
✅ 30 essential steps for successful Food Testing
With this checklist, save time by having the details of all the steps to:
👉 Set up your control plan
👉 Select your subcontracting laboratories
👉 Manage the quality control of batches
You will also find tips, resources, and tools to facilitate your quality control analyses!
Quality control professionals trust CIKLab !




